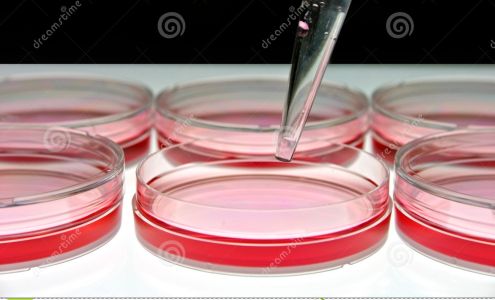

Find Local Businesses In Las Vegas
Loc8NearMe is the easiest and quickest way to find your nearest store, restaurant, gas station, pharmacy or bank branch locations in Las Vegas, Nevada.

Most Popular

Metro by T-Mobile
Metro by T-Mobile
50 locations
O'Reilly Auto Parts
O'Reilly Auto Parts
29 locations
Quest Diagnostics
Quest Diagnostics
9 locations
Dollar General
Dollar General
8 locations
Ace Hardware
Ace Hardware
5 locations
NAPA Auto Parts
NAPA Auto Parts
4 locations
Salvation Army
Salvation Army
2900 Palomino Ln, Las VegasRecently Added Businesses

Las Vegas Cannabis Dispensary CannaStarz
Las Vegas Cannabis Dispensary CannaStarz
631 S Las Vegas Blvd, Las Vegas
IV Drip 2 U Mobile IV Therapy - Las Vegas
IV Drip 2 U Mobile IV Therapy - Las Vegas
2660 S Rainbow Blvd f109, Las Vegas
63 CityCenter
63 CityCenter
3716 S Las Vegas Blvd, Las Vegas
Taffer's Tavern Headquarters
Taffer's Tavern Headquarters
127 E Warm Springs Rd, Las Vegas
Valor Technical Cleaning
Valor Technical Cleaning
2695 N Lamb Blvd Ste #120, Las Vegas
Evora Vegas
Evora Vegas
6111 S Buffalo Dr Suite 140, Las Vegas
Evora Vegas
Evora Vegas
6111 S Buffalo Dr Suite 140, Las Vegas
The Collective
The Collective
3900 Paradise Rd, Las Vegas
Shining Light Hospice
Shining Light Hospice
3265 N Fort Apache Rd #150, Las Vegas
U-Haul Neighborhood Dealer
U-Haul Neighborhood Dealer
7250 S Durango Dr #130, Las Vegas
The Nestled Recovery Center
The Nestled Recovery Center
2860 S Bronco St, Las Vegas
Move 4 Less - Movers Summerlin
Move 4 Less - Movers Summerlin
1180 N Town Center Dr suite 100-1069, Las Vegas
USA Lock & Key
USA Lock & Key
720 E Charleston Blvd Suit 155, Las Vegas
Pandorica Headshot Studio
Pandorica Headshot Studio
9480 S Eastern Ave #258, Las VegasRetail & Shopping
Department & Specialty Stores
Department Stores
Department Stores in Las Vegas
Brazil Station
Brazil Station
5191 W Charleston Blvd #190, Las Vegas
Curacao Las Vegas
Curacao Las Vegas
4200 Meadows Ln, Las VegasConvenience Stores
Convenience Stores in Las Vegas
XO Mini Mart & Liquor
XO Mini Mart & Liquor
953 E Sahara Ave F, Las Vegas
Family Outlet
Family Outlet
7385 W Sahara Ave #1, Las Vegas
ABC Stores #104
ABC Stores #104
3771 Las Vegas Blvd S #130, Las Vegas
Quicky's Convenience Center
Quicky's Convenience Center
4400 N Jones Blvd, Las Vegas
Mercadito UnCommons Las Vegas
Mercadito UnCommons Las Vegas
6815 Tom Rodriguez St Suite 110, Las Vegas
ABC Stores
ABC Stores
3663 S Las Vegas Blvd #145, Las Vegas
Value Market
Value Market
1510 E Sahara Ave, Las Vegas
Joshan Filipino Oriental Market
Joshan Filipino Oriental Market
6325 E Russell Rd, Las Vegas
Short Line Express Market
Short Line Express Market
7730 S Jones Blvd, Las Vegas
MR Mini Mart&Wings
MR Mini Mart&Wings
3860 South Nellis Boulevard, Las Vegas
Pocket Change
Pocket Change
5020 E Tropicana Ave # 2A, Las Vegas
ABC Stores #101
ABC Stores #101
23 Fremont St, Las Vegas
ABC Stores
ABC Stores
378 E Tropicana Ave Space 100, Las VegasGrocery Stores
Grocery Stores in Las Vegas
Trader Joe's
Trader Joe's
7575 W Washington Ave, Las Vegas
European Delicacies
European Delicacies
7835 South Rainbow BlvdSuite 11-12, Las Vegas
Trader Joe's
Trader Joe's
5639 Centennial Center Blvd, Las Vegas
Laos Asia Market
Laos Asia Market
Pecos McLeod Plaza, 3050 E Desert Inn Rd # 108, Las Vegas
Trader Joe's
Trader Joe's
2315 Summa Dr Ste 100, Las Vegas
Japan Creek Market
Japan Creek Market
9310 S Eastern Ave #115, Las Vegas
365 MOUNTAIN MARKET (KOSHER SUPER MARKET)
365 MOUNTAIN MARKET (KOSHER SUPER MARKET)
3655 S Rainbow Blvd #104, Las Vegas
India British Market
India British Market
560 E Windmill Ln #120, Las Vegas
Hungarian Market
Hungarian Market
6380 S Eastern Ave # 6, Las Vegas
Kosher Market
Kosher Market
2521 S Fort Apache Rd, Las Vegas
Southwest Marketplace
Southwest Marketplace
7910-8060 S Rainbow Blvd, Las Vegas
Grocery Outlet
Grocery Outlet
3890 Blue Diamond Rd B, Las Vegas
Omega Mart
Omega Mart
3215 S Rancho Dr #100, Las Vegas
La Tapatia Market
La Tapatia Market
8826 S Eastern Ave #100-102, Las Vegas
La Paloma Meat Market
La Paloma Meat Market
5482 E Lake Mead Blvd, Las VegasSupermarkets
Supermarkets in Las Vegas
WinCo Foods
WinCo Foods
7501 Washington Ave, Las Vegas
WinCo Foods
WinCo Foods
6101 N Decatur Blvd, Las Vegas
Souvenir Super Mart
Souvenir Super Mart
322 Fremont St #108, Las Vegas
Los Compadres
Los Compadres
4381 Stewart Ave, Las Vegas
Marketon Supermarket
Marketon Supermarket
755 N Nellis Blvd #1, Las Vegas
Dondiego’s jewelry repair
Dondiego’s jewelry repair
1560 N Eastern Ave suite f-2, Las Vegas
Mariana's SuperMarkets
Mariana's SuperMarkets
3631 W Sahara Ave, Las Vegas
Cardenas Markets
Cardenas Markets
2545 S Eastern Ave, Las Vegas
Marketon Supermarket
Marketon Supermarket
3736 E Desert Inn Rd, Las Vegas
Mariana's Supermarkets
Mariana's Supermarkets
574 N Eastern Ave, Las Vegas
Marketon Supermarket
Marketon Supermarket
840 N Decatur Blvd, Las Vegas
Owens Avenue Supermarket
Owens Avenue Supermarket
4740 E Owens Ave, Las Vegas
La Bonita Supermarket
La Bonita Supermarket
2405 E Ogden Ave, Las Vegas
Marianas Supermarket
Marianas Supermarket
268 N Jones Blvd, Las Vegas
Jerk Dat Juice Bar and Caribbean Market
Jerk Dat Juice Bar and Caribbean Market
4718 E Flamingo Rd, Las VegasDiscount Stores
Discount Stores in Las Vegas
Raeburn's Discount Outlet
Raeburn's Discount Outlet
6326 S Pecos Rd #1, Las Vegas
Discount Depot
Discount Depot
4590 W Sahara Ave Suite 103, Las Vegas
Half Price Furniture Las Vegas
Half Price Furniture Las Vegas
4449 W Charleston Blvd, Las Vegas
Eastern indoor swapmeet
Eastern indoor swapmeet
1560 N Eastern Ave, Las Vegas
Wolfx Liquidation and Wholesale
Wolfx Liquidation and Wholesale
3230 Polaris Ave Suite 34, Las Vegas
Vera Bradley Factory Outlet
Vera Bradley Factory Outlet
7400 S Las Vegas Blvd space 0036a, Las Vegas
Liquidation center las vegas
Liquidation center las vegas
6015 S Rainbow Blvd, Las Vegas
+ Super 99 Center +
+ Super 99 Center +
2264 S Nellis Blvd, Las VegasThrift Stores
Thrift Stores in Las Vegas
Dog Junkies Thrift Store
Dog Junkies Thrift Store
4324 N Decatur Blvd, Las Vegas
Deseret Industries Thrift Store & Donation Center
Deseret Industries Thrift Store & Donation Center
4655 E Flamingo Rd, Las Vegas
Assistance League of Las Vegas Thrift Shop
Assistance League of Las Vegas Thrift Shop
6446 W Charleston Blvd, Las Vegas
Airman's Attic
Airman's Attic
Las Vegas
Catholic Charities of Southern Nevada
Catholic Charities of Southern Nevada
Administration Office, 1501 Las Vegas Blvd N, Las Vegas
Goodwill Retail Store and Donation Center
Goodwill Retail Store and Donation Center
3345 E Tropicana Ave, Las Vegas
UNLV Surplus Center
UNLV Surplus Center
1325 E Flamingo Rd Suite C, Las Vegas
Goodwill Thrift Store and Donation Center
Goodwill Thrift Store and Donation Center
8970 Westwind Rd, Las Vegas
Treasure House
Treasure House
2000 S Maryland Pkwy # 1, Las Vegas
Goodwill Retail Store and Donation Center
Goodwill Retail Store and Donation Center
330 E Silverado Ranch Blvd, Las Vegas
Goodwill Retail Store and Donation Center
Goodwill Retail Store and Donation Center
348 N Nellis Blvd, Las Vegas
Goodwill Retail Store and Donation Center
Goodwill Retail Store and Donation Center
9230 S Eastern Ave, Las VegasApparel & Accessories
Clothing Stores
Clothing Stores in Las Vegas
American Eagle Outlet
American Eagle Outlet
605 S Grand Central Pkwy Unit 1201, Las Vegas
Quiksilver
Quiksilver
3663 S Las Vegas Blvd Space H - 123, Las Vegas
Quiksilver
Quiksilver
625 S Grand Central Pkwy #1247, Las Vegas
For the love, LV
For the love, LV
1114 S Main St, Las Vegas
Cash 4 Chaos
Cash 4 Chaos
4110 S Maryland Pkwy Suite #28, Las Vegas
Las Vegas Tactical
Las Vegas Tactical
953 E Sahara Ave, Las Vegas
Aroma Retail
Aroma Retail
5525 S Valley View Blvd UNIT 2, Las Vegas
Manga Hole Vegas
Manga Hole Vegas
4266 Spring Mountain Rd Unit 201, Las Vegas
CMC Boutique
CMC Boutique
1401 N Decatur Blvd Ste #31, Las Vegas
Akin Cooperative
Akin Cooperative
1325 S Commerce St, Las Vegas
RICH & ROTTEN
RICH & ROTTEN
3200 S Las Vegas Blvd, Las Vegas
Nike Clearance Store - Las Vegas South
Nike Clearance Store - Las Vegas South
7400 S Las Vegas Blvd Box 1, Las VegasShoe Stores
Shoe Stores in Las Vegas
Las Vegas Uniforms
Las Vegas Uniforms
967 E Sahara Ave, Las Vegas
Zeba Shoes
Zeba Shoes
3843 Spring Mountain Rd, Las Vegas
Performance Footwear
Performance Footwear
9151 W Sahara Ave #103, Las Vegas
Red Wing - Las Vegas, NV
Red Wing - Las Vegas, NV
5060 S Fort Apache Rd STE 120, Suite 120, Las Vegas
Foot Solutions Las Vegas
Foot Solutions Las Vegas
2257 N Rampart Blvd, Las Vegas
Desert Birkenstock
Desert Birkenstock
2021 N Rainbow Blvd #104, Las Vegas
SKECHERS Warehouse Outlet
SKECHERS Warehouse Outlet
1495 E Flamingo Rd, Las Vegas
Hibbett Sports
Hibbett Sports
4620 W Sahara Ave Space 4620-3 & 4624-1, Las Vegas
Freebird Stores - Fashion Show
Freebird Stores - Fashion Show
3200 Las Vegas Blvd S Suite 1380, Las Vegas
Cavender's Boot City
Cavender's Boot City
3200 Las Vegas Blvd S Suite 1320, Las Vegas
ALDO Outlet
ALDO Outlet
795 S Grand Central Pkwy #2247, Las Vegas
SKECHERS Warehouse Outlet
SKECHERS Warehouse Outlet
305 N Nellis Blvd #105, Las Vegas
Shoeworks / Industrial Shoe Company
Shoeworks / Industrial Shoe Company
3620 W Sahara Ave # W8, Las Vegas
SKECHERS Warehouse Outlet
SKECHERS Warehouse Outlet
1191 S Decatur Blvd, Las VegasJewelry Stores
Jewelry Stores in Las Vegas
Desert Diamond Jewelers
Desert Diamond Jewelers
9310 S Eastern Ave #103, Las Vegas
The Gold & Diamond Company
The Gold & Diamond Company
4300 Meadows Ln Suite 2480, Las Vegas
IceBerg Diamonds at Boulevard
IceBerg Diamonds at Boulevard
3552 S Maryland Pkwy, Las Vegas
Huntington Jewelers
Huntington Jewelers
1990 Village Center Cir #6, Las Vegas
Gold and Beyond
Gold and Beyond
376 W Sahara Ave, Las Vegas
The Jewelry District
The Jewelry District
4300 Meadows Ln Suite 2060 Second Floor, Las Vegas
Sky Diamonds
Sky Diamonds
6539 S Las Vegas Blvd C112, Las Vegas
T-Bird Jewels
T-Bird Jewels
1013 S Rampart Blvd, Las Vegas
D&R House of Diamonds
D&R House of Diamonds
1980 Festival Plaza Dr # 440, Las Vegas
MJ Christensen Diamonds
MJ Christensen Diamonds
8980 W Charleston Blvd, Las Vegas
Kay Jewelers
Kay Jewelers
3200 S Las Vegas Blvd # 2710, Las Vegas
The Jewelers of Las Vegas
The Jewelers of Las Vegas
8502 W Lake Mead Blvd # A1, Las Vegas
Queendom Cultivation
Queendom Cultivation
8450 W Sahara Ave suite 109-110, Las Vegas
Zevar Jewelers
Zevar Jewelers
3200 Las Vegas Blvd S Ste 1615, Las Vegas
KAY Jewelers
KAY Jewelers
3663 Las Vegas Blvd S Suite 250, Las VegasHome & Electronics
Home Goods Stores

Aras Mattress & Furniture
Aras Mattress & Furniture
1801 S Rainbow Blvd Ste # 130, Las Vegas
Santa's Wrap
Santa's Wrap
9850 S Maryland Pkwy #4, Las Vegas
Pretty Home
Pretty Home
5825 W Sahara Ave Suite D, Las Vegas
Kirkland's Home
Kirkland's Home
2310 Park Centre Dr Suite 160, Las Vegas
The Container Store
The Container Store
6521 Las Vegas Blvd S C-103, Las Vegas
LG Gallery
LG Gallery
8125 W Sahara Ave STE 130, Las Vegas
Royal Appliances
Royal Appliances
3231 N Decatur Blvd Ste 131, Las Vegas
Zen D'Core
Zen D'Core
4225 Spring Mountain Rd C103, Las Vegas
Urban Jungle Scents
Urban Jungle Scents
1825 Festival Plaza Dr, Las Vegas
All For Our Country
All For Our Country
1028 E Fremont St Suite 170, Las Vegas
HFB Liquidation
HFB Liquidation
2760 S Highland Dr, Las Vegas
NurtureLux Sleep Co
NurtureLux Sleep Co
9811 West Charleston Boulevard Suite 2-253, Las Vegas
Magic Graphics Design & Printing
Magic Graphics Design & Printing
#G#, 4530 E Charleston Blvd, Las VegasFurniture Stores
Furniture Stores in Las Vegas
Furniture For Life - Massage Chairs
Furniture For Life - Massage Chairs
3883 Spring Mountain Rd, Las Vegas
Walker Furniture
Walker Furniture
285 S Martin L King Blvd, Las Vegas
Irish Peddlers Furniture Emporium
Irish Peddlers Furniture Emporium
708 N Nellis Blvd, Las Vegas
AR Furniture
AR Furniture
1717 S Decatur Blvd, Las Vegas
Half Price Furniture & Mattress Store of Las Vegas
Half Price Furniture & Mattress Store of Las Vegas
3625 S Rainbow Blvd, Las Vegas
Mattress Firm Rainbow Blvd
Mattress Firm Rainbow Blvd
7240 S Rainbow Blvd Suite B, Las Vegas
The Vanity Store
The Vanity Store
3347 South Highland Drive, Las Vegas
Half Price Furniture & Mattress Store of Las Vegas
Half Price Furniture & Mattress Store of Las Vegas
163 N Nellis Blvd, Las Vegas
Conn's HomePlus
Conn's HomePlus
3185 E Tropicana Ave, Las Vegas
Furniture World Superstores
Furniture World Superstores
2625 S Maryland Pkwy, Las Vegas
American Freight - Appliance, Furniture, Mattress
American Freight - Appliance, Furniture, Mattress
4854 W Lone Mountain Rd, Las Vegas
Bassett Furniture
Bassett Furniture
1825 Festival Plaza Dr #140, Las Vegas
Reclaimed Secrets
Reclaimed Secrets
2912 S Highland Dr Unit F, Las Vegas
Commercial Liquidators Of America Las Vegas
Commercial Liquidators Of America Las Vegas
4830 W Oquendo Rd, Las VegasMattress Stores
Mattress stores in Las Vegas
Mattress Firm Clearance Center Centennial
Mattress Firm Clearance Center Centennial
6515 N Buffalo Dr STE 120, Las Vegas
Mattress Firm Crossroads Towne Center
Mattress Firm Crossroads Towne Center
6482 North Decatur Boulevard Suite H100B, Las Vegas
Mattress Firm Nellis
Mattress Firm Nellis
196 N Nellis Blvd, Las Vegas
Mattress Firm Boca Park
Mattress Firm Boca Park
8950 West Charleston Boulevard Suite 9 and 10, Las Vegas
Tempur-Pedic Flagship Store
Tempur-Pedic Flagship Store
11015 Sage Park Dr Suite 100, Las Vegas
Mattress Firm Silverado Ranch
Mattress Firm Silverado Ranch
9731 S Eastern Ave Ste A1, Las Vegas
Mattress Firm Best in the West
Mattress Firm Best in the West
2120 N Rainbow Blvd, Las Vegas
Mattress Firm Tropicana Centre
Mattress Firm Tropicana Centre
3175 E Tropicana Ave Ste A, Las Vegas
Mattress Firm Serene
Mattress Firm Serene
1920 E Serene Ave Suite 530, Las Vegas
Mattress Firm Grand Canyon
Mattress Firm Grand Canyon
4145 S Grand Canyon Dr, Las Vegas
Mattress Firm Blue Diamond
Mattress Firm Blue Diamond
3815 Blue Diamond Rd Suite 105, Las Vegas
Mattress Firm Fort Apache
Mattress Firm Fort Apache
5195 S Fort Apache Rd Suite 105, Las Vegas
Best Mattress
Best Mattress
4120 Blue Diamond Rd, Las Vegas
Best Mattress
Best Mattress
7355 S Rainbow Blvd Suite 130, Las Vegas
Best Mattress
Best Mattress
Parking lot, 5095 S Fort Apache Rd, Las VegasElectronics
Electronics in Las Vegas
Neon Production Supply
Neon Production Supply
3625 W Teco Ave UNIT 3, Las Vegas
Best Deal In Town - The #1 TV and Apple Store in Las Vegas
Best Deal In Town - The #1 TV and Apple Store in Las Vegas
6811 S Eastern Ave #103, Las Vegas
Coltan Electronics
Coltan Electronics
3555 Las Vegas Blvd S, Las Vegas
Audio Xpert
Audio Xpert
2120 E Charleston Blvd, Las Vegas
repairsuniverse
repairsuniverse
3315 E Russell Rd suite a-4-127, Las Vegas
Kiesub Electronics
Kiesub Electronics
3185 S Highland Dr #10, Las Vegas
Technology Galaxy
Technology Galaxy
Parking lot, 7065 W Ann Rd #130, Las Vegas
Walgreens Photo
Walgreens Photo
3765 S Las Vegas Blvd, Las Vegas
Casa Latina Records
Casa Latina Records
Las Vegas
Apple The Forum Shops
Apple The Forum Shops
Caesars Palace, 3500 S Las Vegas Blvd, Las Vegas
Progressive Smart Homes
Progressive Smart Homes
6280 S Valley View Blvd #722, Las VegasHealth & Beauty
Pharmacies
Pharmacies in Las Vegas
Prosource Pharmacy
Prosource Pharmacy
6530 S Buffalo Dr #110, Las Vegas
Credo Pharmacy
Credo Pharmacy
8995 W Flamingo Rd Suite 120, Las Vegas
Solutions Specialty Pharmacy
Solutions Specialty Pharmacy
8579 S Eastern Ave, Las Vegas
986 Specialty Pharmacy
986 Specialty Pharmacy
321 N Buffalo Dr STE 120, Las Vegas
QHR Pharmacy
QHR Pharmacy
7512 Westcliff Dr, Las Vegas
Vesper Specialty Pharmacy
Vesper Specialty Pharmacy
4225 S Eastern Ave #16, Las Vegas
Assist Care Pharmacy
Assist Care Pharmacy
3045 E Post Rd, Las Vegas
City Pharmacy
City Pharmacy
1131 E Tropicana Ave Suite A, Las Vegas
American Wellness Pharmacy
American Wellness Pharmacy
2775 S Jones Blvd #100A, Las Vegas
Silver State Pharmacy LLC
Silver State Pharmacy LLC
1591 N Buffalo Dr Suite-140, Las Vegas
Apotheco Pharmacy Choice Las Vegas
Apotheco Pharmacy Choice Las Vegas
7915 W Sahara Ave #103, Las Vegas
All In One Pharmacy
All In One Pharmacy
2080 E Flamingo Rd, Las Vegas
LV Pharmacy & Medical Supplies
LV Pharmacy & Medical Supplies
4503 West Sahara Avenue Unit 170, Las VegasBeauty Salons

Perfect Eyebrows
Perfect Eyebrows
240 S Decatur Blvd, Las Vegas
Square Salon +
Square Salon +
1225 S Fort Apache Rd #160, Las Vegas
Safa Elite Eyebrows
Safa Elite Eyebrows
8751 W Charleston Blvd Ste 150, Las Vegas
LOOK Style Society
LOOK Style Society
6539 S Las Vegas Blvd Suite 110, Las Vegas
Kriti Eyebrows Threading
Kriti Eyebrows Threading
5466 Boulder Hwy, Las Vegas
Bloom Salon & Med Spa
Bloom Salon & Med Spa
8090 Blue Diamond Rd #180, Las Vegas
The Studio Hue Salon : Aveda
The Studio Hue Salon : Aveda
7965 S Rainbow Blvd #155, Las Vegas
Showtime Nail Las Vegas
Showtime Nail Las Vegas
351 E Silverado Ranch Blvd Ste 115, Las Vegas
Hue Salon & Spa
Hue Salon & Spa
4245 S Grand Canyon Dr # 100, Las Vegas
HOTBOX salon
HOTBOX salon
2075 E Windmill Ln #130, Las Vegas
Em Purities Beauty
Em Purities Beauty
5818 Spring Mountain Rd STE 214, Las Vegas
Mosaic Salon Boutique
Mosaic Salon Boutique
9550 S Eastern Ave, Las Vegas
Epiphany Salons
Epiphany Salons
4001s N, 4001 S Buffalo Dr, Las Vegas
g Aveda Salon Mountains Edge
g Aveda Salon Mountains Edge
7955 Blue Diamond Rd, Las Vegas
Inspired Beauty Salon
Inspired Beauty Salon
9850 S Maryland Pkwy #14-405, Las VegasHair Salons

NY Hair Company
NY Hair Company
1550 E Tropicana Ave ste 1, Las Vegas
Atomic Style Lounge
Atomic Style Lounge
1237 S Main St, Las Vegas
VIVA Hair Studio | Natural Hair Stylist
VIVA Hair Studio | Natural Hair Stylist
9037 W Sahara Ave, Las Vegas
The Hair Standard
The Hair Standard
10247 W Charleston Blvd, Las Vegas
Bombshell Brazilian Waxing & Beauty Lounge
Bombshell Brazilian Waxing & Beauty Lounge
150 Las Vegas Blvd N Suite 140, Las Vegas
Dare to Dye Salon Boutique
Dare to Dye Salon Boutique
9710 W Tropicana Ave #115, Las Vegas
A Perfect Hue Salon - Las Vegas
A Perfect Hue Salon - Las Vegas
7377 S Jones Blvd suite 112, Las Vegas
Joy's Secrets Hair Studio
Joy's Secrets Hair Studio
1620 S Decatur Blvd H, Las Vegas
Vegas Hair Color Masters
Vegas Hair Color Masters
8174 Las Vegas Blvd S #105, Las Vegas
Angie's Salon
Angie's Salon
4985 S Fort Apache Rd #102, Las Vegas
Bliss Spa and Salon
Bliss Spa and Salon
3950 East Sunset Road #117, #118 and #119, Las Vegas
Hottie Hair Salon & Extensions Store
Hottie Hair Salon & Extensions Store
7871 W Charleston Blvd #160, Las Vegas
Viva Hair Studio | Natural Hair Stylist
Viva Hair Studio | Natural Hair Stylist
10870 W Charleston Blvd #120, Las Vegas
Raw Remedies - Natural Hair Care Las Vegas
Raw Remedies - Natural Hair Care Las Vegas
203 E Colorado Ave, Las VegasNail Salons

Queen Nails & Spa
Queen Nails & Spa
450 S Buffalo Dr APT 108, Las Vegas
Top Nails LLC
Top Nails LLC
4550 S Maryland Pkwy #22, Las Vegas
J & K Nail Spa
J & K Nail Spa
3945 S Durango Dr A3, Las Vegas
Warm Spring Nail Spa
Warm Spring Nail Spa
7161 S Eastern Ave e3, Las Vegas
Star Nails & Spa
Star Nails & Spa
6530 S Decatur Blvd Suite #115, Las Vegas
Mia Nail Spa Las Vegas
Mia Nail Spa Las Vegas
8645 S Rainbow Blvd #140, Las Vegas
Ireh nail by yuna(이레네일)
Ireh nail by yuna(이레네일)
10300 W Charleston Blvd Suite17 B01, Las Vegas
Chloe Beauty
Chloe Beauty
1750 S Rainbow Blvd #15, Las Vegas
Lovely Nails
Lovely Nails
1969 5693 S Jones Blvd # 104, Las Vegas
Modern Nails
Modern Nails
9555 S Eastern Ave #110, Las Vegas
Polished Nails & Spa
Polished Nails & Spa
7575 S Rainbow Blvd UNIT 107, Las Vegas
Fantastic Nails
Fantastic Nails
9285 S Cimarron Rd # 115, Las Vegas
Nails By Sasha
Nails By Sasha
6871 West Charleston Boulevard, Las Vegas
Top Nails - Meadows Ln
Top Nails - Meadows Ln
4640 Meadows Ln #140, Las Vegas
Q Nails & Spa
Q Nails & Spa
7995 W Sahara Ave, Las VegasCosmetics & Beauty

Benefit Cosmetics BrowBar
Benefit Cosmetics BrowBar
Macy's, 3200 S Las Vegas Blvd, Las Vegas
Creed Boutique Las Vegas Crystals
Creed Boutique Las Vegas Crystals
3720 S Las Vegas Blvd #205, Las Vegas
The Barber Company
The Barber Company
2580 S Decatur Blvd, Las Vegas
G’s Hair and Beauty Supply
G’s Hair and Beauty Supply
3035 Tropicana Ave Ste G, Las Vegas
Baroque Beauty Center
Baroque Beauty Center
3100 S Durango Dr #102, Las Vegas
Lux Beauty Supply
Lux Beauty Supply
1159 E Twain Ave suite 109, Las Vegas
Lush Cosmetics Fashion Show Mall
Lush Cosmetics Fashion Show Mall
3200 S Las Vegas Blvd Suite 1330, Las Vegas
Lip Lab Fashion Show Mall
Lip Lab Fashion Show Mall
3200 S Las Vegas Blvd Suite 2180, Las Vegas
Bath & Body Works
Bath & Body Works
9827 S EASTERN AVE, Las Vegas
Bath & Body Works
Bath & Body Works
4300 Meadows Ln, Las Vegas
Lush Cosmetics Miracle Mile
Lush Cosmetics Miracle Mile
3663 S Las Vegas Blvd, Las Vegas
Lux Beauty Supply
Lux Beauty Supply
290 S Decatur Blvd, Las Vegas
Jouvence Éternelle
Jouvence Éternelle
5757 Wayne Newton Blvd, Las Vegas
R love beauty supply
R love beauty supply
8370 W Cheyenne Ave #108, Las Vegas
AGORA Cosmetics
AGORA Cosmetics
4260 Cameron St, Las VegasHobbies & Special Interest
Sporting Goods
Sporting Goods in Las Vegas
Las Vegas Golf Superstore
Las Vegas Golf Superstore
4711 Dean Martin Dr, Las Vegas
Bass Pro Shops
Bass Pro Shops
8200 Dean Martin Dr, Las Vegas
Desert Rock Sports
Desert Rock Sports
8221 W Charleston Blvd, Las Vegas
Lucky Disc Golf
Lucky Disc Golf
2301 Sunset Rd Suite 10, Las Vegas
Big 5 Sporting Goods
Big 5 Sporting Goods
9540 S Eastern Ave, Las Vegas
Big 5 Sporting Goods
Big 5 Sporting Goods
1140 S Decatur Blvd, Las Vegas
All Martial Arts Supplies and self defence supplies
All Martial Arts Supplies and self defence supplies
4025 W Charleston Blvd, Las Vegas
Big 5 Sporting Goods
Big 5 Sporting Goods
6720 N Durango Dr Suite 110, Las Vegas
Big 5 Sporting Goods
Big 5 Sporting Goods
Parking lot, 3975 S Buffalo Dr #103, Las Vegas
Big 5 Sporting Goods
Big 5 Sporting Goods
3265 E Tropicana Ave UNIT 39, Las Vegas
Las Vegas Fight Shop
Las Vegas Fight Shop
7400 Las Vegas Blvd S Suite 212, Las Vegas
Marucci Clubhouse Las Vegas
Marucci Clubhouse Las Vegas
7155 S Buffalo Dr, Las Vegas
9 Dragons Fight Shop
9 Dragons Fight Shop
3375 S Decatur Blvd #7, Las VegasAutomotive & Transportation
Auto Dealers

Centennial Subaru
Centennial Subaru
6350 Centennial Center Blvd, Las Vegas
Las Vegas Auto Sports
Las Vegas Auto Sports
4365 S, Cameron St, Las Vegas
Vegas Auto Gallery Lotus Las Vegas
Vegas Auto Gallery Lotus Las Vegas
5530 Rafael Rivera Wy, Las Vegas
Car Rental Las Vegas - Van, Suv, Luxury
Car Rental Las Vegas - Van, Suv, Luxury
6295 Harrison Dr #1, Las Vegas
Universal Motorcars
Universal Motorcars
5585 Spring Mountain Rd, Las Vegas
Sahara Auto Sales
Sahara Auto Sales
1590 E Sahara Ave, Las Vegas
Charlie Cheap Car
Charlie Cheap Car
5015 W Sahara Ave UNIT 127, Las Vegas
Las Vegas Motor Speedway
Las Vegas Motor Speedway
7000 Las Vegas Blvd N, Las Vegas
Subaru of Las Vegas
Subaru of Las Vegas
6455 W Roy Horn Way, Las Vegas
WEST COAST AUTO REMARKETING
WEST COAST AUTO REMARKETING
2961 Westwood Dr, Las Vegas
Automax of Las Vegas
Automax of Las Vegas
3141 E Fremont St, Las Vegas
Sunrise Auto Sales
Sunrise Auto Sales
939 N Nellis Blvd, Las Vegas
LoanStar Auto Sales
LoanStar Auto Sales
3720 Sunset Rd Suite 104A, Las Vegas
Las Dunas Auto Sales
Las Dunas Auto Sales
1250 N Eastern Ave, Las VegasAuto Repair
Car Repair in Las Vegas
Quantum Mechanics Auto Repair
Quantum Mechanics Auto Repair
3230 N Durango Dr, Las Vegas
Adams Driveshaft Inc.
Adams Driveshaft Inc.
6265 Stevenson Way, Las Vegas
Gaudin Porsche of Las Vegas
Gaudin Porsche of Las Vegas
6800 Redwood St, Las Vegas
G & G Autohaus
G & G Autohaus
325 S Decatur Blvd, Las Vegas
Zip Zap Auto
Zip Zap Auto
3220 N Durango Dr, Las Vegas
Battle Born Offroad
Battle Born Offroad
4301 S Valley View Blvd #19, Las Vegas
Asian Imports
Asian Imports
10177 W Charleston Blvd, Las Vegas
Integrity Mobile Auto Service
Integrity Mobile Auto Service
5115 Dean Martin Dr UNIT 503, Las Vegas
5 Star Auto Repair
5 Star Auto Repair
6396 W Sahara Ave, Las Vegas
Busy Boots Automotive
Busy Boots Automotive
4160 S Durango Dr #110, Las Vegas
A Arrow Alignment
A Arrow Alignment
5441 S Decatur Blvd, Las Vegas
Wally's Precision Auto Care
Wally's Precision Auto Care
3290 Pinks Pl, Las Vegas
Courtesy Auto Repair & Service
Courtesy Auto Repair & Service
7035 W Sahara Ave # 500, Las Vegas
Auto Dynamic Services LLC
Auto Dynamic Services LLC
5850 La Costa Canyon Ct, Las VegasCar Wash
Car Wash in Las Vegas
Gloss-It Auto Detailing Studio
Gloss-It Auto Detailing Studio
5032 W Post Rd, Las Vegas
Swangin Auto Detail LLC
Swangin Auto Detail LLC
5622 Lago Ct, Las Vegas
Red Bro's Drive-Thru Smog Check
Red Bro's Drive-Thru Smog Check
6015 Spring Mountain Rd, Las Vegas
Las Vegas Hand Car Wash
Las Vegas Hand Car Wash
5680 S Pecos Rd, Las Vegas
ECO'S AUTO DETAIL
ECO'S AUTO DETAIL
304 N Wallace Dr, Las Vegas
Finity High End Detailing
Finity High End Detailing
3651 S Lindell Rd d1114, Las Vegas
Diaz Detailing & Professional Car Wash
Diaz Detailing & Professional Car Wash
5715 S Pecos Rd, Las Vegas
Vegas Suds Carwash
Vegas Suds Carwash
3810 N Jones Blvd, Las Vegas
GO Car Wash
GO Car Wash
3265 S Nellis Blvd, Las Vegas
Haddies Chevron & Luxury Express Car Wash
Haddies Chevron & Luxury Express Car Wash
9920 W Flamingo Rd, Las Vegas
WOW Carwash - Buffalo Drive (Las Vegas)
WOW Carwash - Buffalo Drive (Las Vegas)
3935 S Buffalo Dr, Las Vegas
WOW Carwash -N. Rancho Dr
WOW Carwash -N. Rancho Dr
4330 N Rancho Dr, Las Vegas
WOW Carwash - N. Pecos
WOW Carwash - N. Pecos
880 North Pecos Road, Las Vegas
U-DRIVE Express Car Wash
U-DRIVE Express Car Wash
6451 W Charleston Blvd, Las VegasGas Stations
Gas Stations in Las Vegas
Costco Gas Station
Costco Gas Station
6555 N Decatur Blvd, Las Vegas
Costco Gas Station
Costco Gas Station
801 S Pavilion Center Dr, Las Vegas
Rainbow Market
Rainbow Market
3887 E Lake Mead Blvd, Las Vegas
Coyote Corner
Coyote Corner
5118 E Lake Mead Blvd, Las Vegas
Sam's Club Gas Station
Sam's Club Gas Station
5101 S Pecos Rd, Las Vegas
Smith's Fuel Center
Smith's Fuel Center
4610 W Cactus Ave, Las Vegas
Funny's II
Funny's II
3550 N Rancho Dr, Las Vegas
All Purpose Auto Repair
All Purpose Auto Repair
2755 N Nellis Blvd, Las Vegas
GAS 4 LESS
GAS 4 LESS
3283 Las Vegas Blvd N, Las VegasServices
Pet Services
Pet Stores
Pet Stores in Las Vegas
Dog Supplies Outlet
Dog Supplies Outlet
6181 S Rainbow Blvd #101, Las Vegas
Pet Supplies Plus Las Vegas - Mountains Edge
Pet Supplies Plus Las Vegas - Mountains Edge
8045 Blue Diamond Rd Ste. 105, Las Vegas
Dog Supplies Outlet
Dog Supplies Outlet
8450 W Sahara Ave #102, Las Vegas
Piggy Tails Pet Spa & More
Piggy Tails Pet Spa & More
7540 Oso Blanca Rd Ste#120, Las Vegas
Las Vegas Aquariums
Las Vegas Aquariums
4545 E Tropicana Ave Suite 4, Las Vegas
Healthy Tails LV
Healthy Tails LV
8457 W Lake Mead Blvd, Las Vegas
Puppy Boutique Las Vegas
Puppy Boutique Las Vegas
4343 N Rancho Dr #244, Las Vegas
Three Dog Bakery Inc
Three Dog Bakery Inc
2110 N Rampart Blvd, Las Vegas
Barking Dogs Self Wash & Grooming Centennial Hills
Barking Dogs Self Wash & Grooming Centennial Hills
7220 W Azure Dr #130, Las Vegas
Barking Dogs Self-Wash & Grooming Mountains Edge
Barking Dogs Self-Wash & Grooming Mountains Edge
9325 S Cimarron Rd, Las Vegas
Pet Planet LLC
Pet Planet LLC
272 S Decatur Blvd, Las Vegas
Ifa Country Store
Ifa Country Store
3176 W Martin Ave, Las Vegas
The Wagging Tail Pet Grocery & Supplies
The Wagging Tail Pet Grocery & Supplies
10170 W Tropicana Ave #157, Las Vegas
Precious Pets Animal Service
Precious Pets Animal Service
6275 Harrison Dr #29, Las Vegas
Bogart's Bone Appetit
Bogart's Bone Appetit
4985 S Fort Apache Rd #105, Las VegasVeterinarians
Veterinarians in Las Vegas
Pet Health Animal Hospital
Pet Health Animal Hospital
8520 W Desert Inn Rd #1, Las Vegas
Rainbow Animal Hospital
Rainbow Animal Hospital
244 S Rainbow Blvd, Las Vegas
Aloha Animal Hospital
Aloha Animal Hospital
7341 S Torrey Pines Dr, Las Vegas
Animal Kindness Veterinary Hospital
Animal Kindness Veterinary Hospital
4910 E Bonanza Rd, Las Vegas
Sandy Hill Animal Clinic
Sandy Hill Animal Clinic
3752 E Tropicana Ave, Las Vegas
Mauer Animal Clinic
Mauer Animal Clinic
6115 W Charleston Blvd, Las Vegas
Desert Pines Equine Center
Desert Pines Equine Center
5000 N Jones Blvd, Las Vegas
Sahara Pines Animal Hospital
Sahara Pines Animal Hospital
6533 W Sahara Ave, Las Vegas
Dewey Veterinary Medical Center
Dewey Veterinary Medical Center
4800 W Dewey Dr, Las Vegas
Advanced Animal Care Hospital
Advanced Animal Care Hospital
8800 W Charleston Blvd # 6, Las Vegas
Park Animal Hospital
Park Animal Hospital
8400 S Eastern Ave, Las Vegas
Sahara Animal Hospital
Sahara Animal Hospital
4301 W Sahara Ave, Las Vegas
Northeast Animal Hospital
Northeast Animal Hospital
4805 E Lake Mead Blvd, Las Vegas
VCA Hualapai Animal Hospital
VCA Hualapai Animal Hospital
1165 S Hualapai Wy, Las Vegas
Sunset Eastern Animal Hospital
Sunset Eastern Animal Hospital
6521 S Eastern Ave, Las VegasFinancial & Insurance
Banks
Banks in Las Vegas
Preferred Trust
Preferred Trust
6700 Via Austi Pkwy Suite 301, Las Vegas
Bank of Nevada
Bank of Nevada
1115 S Hualapai Way, Las Vegas
Bank of Nevada
Bank of Nevada
8505 W Centennial Pkwy, Las Vegas
Bank of Nevada
Bank of Nevada
2700 W Sahara Ave, Las Vegas
Bank of Nevada
Bank of Nevada
100 S City Pkwy Ste. 120, Las Vegas
Aloha Pacific Federal Credit Union
Aloha Pacific Federal Credit Union
9555 S Eastern Ave #150, Las Vegas
First Foundation Bank
First Foundation Bank
6725 Via Austi Pkwy #100, Las Vegas
Koroghli Family Trust Eastern
Koroghli Family Trust Eastern
4225 S Eastern Ave, Las Vegas
Bank of Nevada
Bank of Nevada
3985 S Durango Dr, Las Vegas
America First Credit Union
America First Credit Union
2699 N Tenaya Way, Las Vegas
1st International Bank
1st International Bank
Parking lot, 6822 W Sahara Ave, Las Vegas
Bank of Nevada
Bank of Nevada
7251 W Lake Mead Blvd Suite 108, Las Vegas
The American Guardian | Safe Deposit Boxes & Private Vaults
The American Guardian | Safe Deposit Boxes & Private Vaults
2381 Renaissance Dr c, Las VegasTax Preparation

The Professional Multiservices
The Professional Multiservices
2590 E Bonanza Rd, Las Vegas
Sonia's Tax Services
Sonia's Tax Services
2801 S Valley View Blvd Suite 6, Las Vegas
Liberty Tax
Liberty Tax
8565 W Sahara Ave #112, Las Vegas
Adam Hodson, CPA
Adam Hodson, CPA
3438 N Buffalo Dr, Las Vegas
Compass Taxes
Compass Taxes
224 S Jones Blvd, Las Vegas
Liberty Tax
Liberty Tax
270 N Jones Blvd, Las Vegas
Liberty Tax
Liberty Tax
1105 S Rainbow Blvd Suite 105, Las Vegas
Kondler & Associates CPAs
Kondler & Associates CPAs
8475 W Sunset Rd UNIT 201, Las Vegas
Liberty Tax
Liberty Tax
3131 N Rancho Dr Suite B, Las Vegas
Jackson Hewitt Tax Service
Jackson Hewitt Tax Service
1780 N Buffalo Dr Suite 108, Las Vegas
Jackson Hewitt Tax Service
Jackson Hewitt Tax Service
1920 E Serene Ave Ste 500-1, Las Vegas
Jackson Hewitt Tax Service
Jackson Hewitt Tax Service
1995 N Nellis Blvd, Las Vegas
Jackson Hewitt Tax Service
Jackson Hewitt Tax Service
901 S. Rancho Drive Ste 13 & 14, Las Vegas
Jackson Hewitt Tax Service
Jackson Hewitt Tax Service
4750 W Sahara Ave Suite 1, Las VegasMoney Transfers
Money Transfers in Las Vegas
Ria Money Transfer - Avanza Multiservicios
Ria Money Transfer - Avanza Multiservicios
Avanza Multiservicios, 3871 S Valley View Blvd Suite 23, Las Vegas
Western Union
Western Union
850 South Rancho Drive, Las Vegas
Western Union
Western Union
8050 S Rainbow Blvd, Las Vegas
PPS Money Center
PPS Money Center
3851 Pennwood Ave #192, Las Vegas
DolEx Dollar Express
DolEx Dollar Express
937 N Pecos Rd, Las Vegas
Order Express
Order Express
537 E Twain Ave, Las Vegas
PNB Remittance Centers, Inc
PNB Remittance Centers, Inc
3890 S Maryland Pkwy Suite G, Las Vegas
Envíos de Dinero Mariana´s
Envíos de Dinero Mariana´s
705 N Eastern Ave, Las Vegas
Western Union
Western Union
8180 Las Vegas Blvd S, Las Vegas
Coinstar Kiosk | Bitcoin ATM
Coinstar Kiosk | Bitcoin ATM
Kroger - Smith's Food & Drug C, 10100 W. Tropicana Ave., 10100 W Tropicana Ave, Las Vegas
Envios La Princesita
Envios La Princesita
3160 E Desert Inn Rd #11, Las Vegas
Western Union
Western Union
9275 W Flamingo Rd Ste 100, Las VegasHealth & Wellness
Fitness & Gyms
Gyms in Las Vegas
Tread Vegas Fitness
Tread Vegas Fitness
4325 Dean Martin Dr Suite 325, Las Vegas
The Strip Crossfit
The Strip Crossfit
4325 Dean Martin Dr #315, Las Vegas
Powerhouse Gym Las Vegas
Powerhouse Gym Las Vegas
1950 S Rainbow Blvd #105, Las Vegas
CrossFit Social City
CrossFit Social City
3665 S Fort Apache Rd #104, Las Vegas
Rugged CrossFit 702
Rugged CrossFit 702
6040 S Fort Apache Rd #101, Las Vegas
F45 Training Summerlin
F45 Training Summerlin
1000 S Rampart Blvd STE 12, Las Vegas
Mayweather Boxing + Fitness
Mayweather Boxing + Fitness
6565 S Fort Apache Rd Ste 165, Las Vegas
CrossFit Raw Appeal
CrossFit Raw Appeal
7091 W Craig Rd # 102, Las Vegas
Yak's Fitness
Yak's Fitness
7375 S Durango Dr #101, Las Vegas
F45 Training Las Vegas Arts District
F45 Training Las Vegas Arts District
1301 S Commerce St Unit 110, Las Vegas
Crossfit Apollo
Crossfit Apollo
6535 N Buffalo Dr #160, Las Vegas
Planet Fitness
Planet Fitness
6564 N Decatur Blvd, Las Vegas
Revolution Fitness Evolved
Revolution Fitness Evolved
3065 E Patrick Ln Ste 2, Las VegasMedical Labs
Medical Labs in Las Vegas
ARCpoint Labs of Las Vegas
ARCpoint Labs of Las Vegas
3365 E Flamingo Rd #4, Las Vegas
EFFEX Analytical Services
EFFEX Analytical Services
5965 Harrison Dr STE 8, Las Vegas
Dr. Thomas Brewer
Dr. Thomas Brewer
8724 Spanish Ridge Ave Ste B, Las Vegas
Phamatech Laboratories & Diagnostics
Phamatech Laboratories & Diagnostics
3650 South Eastern Avenue STE 300, Las Vegas
Quest Diagnostics
Quest Diagnostics
7891 W Tropical Pkwy Suite 110, Las Vegas
American Specialty Lab
American Specialty Lab
7251 W Charleston Blvd, Las Vegas
Viticus Center - Oquendo Campus
Viticus Center - Oquendo Campus
2425 E Oquendo Rd, Las Vegas
Digipath Labs
Digipath Labs
6450 Cameron St #113, Las Vegas
Clinical Pathology Laboratories (CPL) - Mountain View
Clinical Pathology Laboratories (CPL) - Mountain View
7180 Cascade Valley Ct Ste 150, Las Vegas
Primex Clinical Laboratories
Primex Clinical Laboratories
2810 W Charleston Blvd #55, Las Vegas
Talent Testing Service, Inc.
Talent Testing Service, Inc.
2121 E Flamingo Rd Ste 106, Las Vegas
Clinical Pathology Laboratories (CPL) - Fort Apache
Clinical Pathology Laboratories (CPL) - Fort Apache
5771 S Fort Apache Rd #110, Las Vegas
Absolute Drug Testing & DNA Paternity Testing
Absolute Drug Testing & DNA Paternity Testing
620 S 11th St #120, Las Vegas
Aloha XPress Medical
Aloha XPress Medical
4510 S Eastern Ave # 9, Las VegasProfessional Services
Movers
Movers in Las Vegas
Move 4 Less - Movers Summerlin
Move 4 Less - Movers Summerlin
1180 N Town Center Dr suite 100-1069, Las Vegas
BMS Moving & Storage
BMS Moving & Storage
4210 Sobb Ave, Las Vegas
LV Reliable Movers
LV Reliable Movers
9570 Newton Grove Ct, Las Vegas
Muscle Movers LLC Las Vegas
Muscle Movers LLC Las Vegas
2410 N Decatur Blvd #115, Las Vegas
Fort Apache Desert Inn Self Storage
Fort Apache Desert Inn Self Storage
3375 S Fort Apache Rd, Las Vegas
Jackie Movers
Jackie Movers
6032 American Beauty Ave, Las Vegas
AAction Movers Of Nevada
AAction Movers Of Nevada
6615 Escondido St Ste E, Las Vegas
Red Carpet Moving Company
Red Carpet Moving Company
5435 S Procyon St #200, Las Vegas
Smart Move Las Vegas Moving Co
Smart Move Las Vegas Moving Co
3838 Raymert Dr suite 310, Las Vegas
Golden State Storage - Rainbow
Golden State Storage - Rainbow
5150 S Rainbow Blvd, Las Vegas
Skyline Moving Service
Skyline Moving Service
7582 Las Vegas Blvd S Suite 184, Las Vegas
Towne Storage - Rainbow
Towne Storage - Rainbow
6995 W Dewey Dr, Las Vegas
College Hunks Hauling Junk and Moving Las Vegas
College Hunks Hauling Junk and Moving Las Vegas
5940 S Rainbow Blvd Suite 2014, Las Vegas
Golden State Storage - Tropicana
Golden State Storage - Tropicana
4888 E Tropicana Ave, Las VegasHome & Repair Services
Hardware Stores
Hardware Stores in Las Vegas
Meads Hardware
Meads Hardware
4438 E Lake Mead Blvd, Las Vegas
Tractor Supply Co.
Tractor Supply Co.
6658 Sky Pointe Dr, Las Vegas
Harbor Freight Tools
Harbor Freight Tools
5780 Centennial Center Blvd, Las Vegas
Harbor Freight Tools
Harbor Freight Tools
3550 Sunset Rd suite b, Las Vegas
McFadden-Dale Industrial Hardware
McFadden-Dale Industrial Hardware
5580 S Decatur Blvd #114, Las Vegas
Harbor Freight Tools
Harbor Freight Tools
2240 S Nellis Blvd suite f-1, Las Vegas
Tractor Supply Co.
Tractor Supply Co.
9060 S Rainbow Blvd, Las Vegas
Woodcraft of Las Vegas
Woodcraft of Las Vegas
5220 W Charleston Blvd #1345, Las Vegas
Purvis Industries
Purvis Industries
3360 W Sunset Rd #1, Las Vegas
Ace Hardware
Ace Hardware
3665 S Rainbow Blvd 100 A-B, Las Vegas
Quickflash Products Inc
Quickflash Products Inc
4129 Wagon Trail Ave, Las Vegas
All Hose Inc. (North)
All Hose Inc. (North)
4300 N Pecos Rd STE 2, Las Vegas
Concrete Accessories Inc
Concrete Accessories Inc
3500 Meade Ave, Las Vegas
Harbor Freight Tools
Harbor Freight Tools
160 S Rainbow Blvd #160, Las Vegas
Grainger Industrial Supply
Grainger Industrial Supply
2401 Western Ave, Las VegasTechnology & Communication
Cell Phone Stores
Mobile Phones in Las Vegas
Silver Wireless Cell Phone Repair
Silver Wireless Cell Phone Repair
1610 E Charleston Blvd #110, Las Vegas
Yes of Course
Yes of Course
4660 W Charleston Blvd, Las Vegas
Cricket Wireless Authorized Retailer
Cricket Wireless Authorized Retailer
3519 S Maryland Pkwy B, Las Vegas
iPhone Wizards
iPhone Wizards
9620 S Las Vegas Blvd Unit N9, Las Vegas
Cricket Wireless Authorized Retailer
Cricket Wireless Authorized Retailer
5516 Boulder Hwy Suite 2B, Las Vegas
Cricket Wireless Authorized Retailer
Cricket Wireless Authorized Retailer
4110 S Maryland Pkwy, Las Vegas
AT&T Store
AT&T Store
7531 W Lake Mead Blvd Suite 101, Las Vegas
Cricket Wireless Authorized Retailer
Cricket Wireless Authorized Retailer
450 E Silverado Ranch Blvd Ste 100, Las Vegas
AT&T Store
AT&T Store
4588 Spring Mountain Rd, Las Vegas
Boost Mobile
Boost Mobile
3025 E Desert Inn Rd #7, Las Vegas
I Phone Clinic
I Phone Clinic
inside Marianas Market, 574 N Eastern Ave, Las Vegas
Cricket Wireless Authorized Retailer
Cricket Wireless Authorized Retailer
3848 W Sahara Ave, Las Vegas
Boost Mobile
Boost Mobile
7500 W Lake Mead Blvd #15, Las VegasFood & Beverage
Specialty Food Stores
Liquor Stores
Liquor Stores in Las Vegas
Liquor Locker
Liquor Locker
4110 S Maryland Pkwy Suite #4, Las Vegas
Crystal Liquor
Crystal Liquor
3655 S Durango Dr # 21, Las Vegas
W Liquor Store
W Liquor Store
3871 W Viking Rd # 14, Las Vegas
Super Liquor McCarran Village - Airport
Super Liquor McCarran Village - Airport
384 E Tropicana Ave #150, Las Vegas
Vegas Homebrew
Vegas Homebrew
5140 W Charleston Blvd, Las Vegas
Strip Liquor
Strip Liquor
3049 S Las Vegas Blvd, Las Vegas
Total Wine & More
Total Wine & More
5720 Centennial Center Blvd, Las Vegas
Liquor World
Liquor World
3301 Western Ave, Las Vegas
Liquor Store Discount Liquor
Liquor Store Discount Liquor
5835 E Sahara Ave, Las Vegas
Spirits & Spice | Las Vegas
Spirits & Spice | Las Vegas
3377 S Las Vegas Blvd # 2035, Las Vegas
Los Primos Liquor
Los Primos Liquor
3488 E Sahara Ave suite 102, Las Vegas
Total Wine & More
Total Wine & More
730 S Rampart Blvd, Las Vegas
Total Wine & More
Total Wine & More
6885 S Las Vegas Blvd, Las Vegas
Ace Liquor
Ace Liquor
3266 Las Vegas Blvd N Suite 5-6, Las Vegas
Lee's Discount Liquor
Lee's Discount Liquor
9110 S Las Vegas Blvd, Las VegasPersonal & Community
Community & Social
Other Categories
Miscellaneous
Pawn Shops
Pawn Shops in Las Vegas
TNT Pawn and Jewelry
TNT Pawn and Jewelry
Parking lot, 7960 W Sahara Ave # 120, Las Vegas
Max Pawn Luxury
Max Pawn Luxury
4050 S Decatur Blvd, Las Vegas
Max Pawn Luxury
Max Pawn Luxury
6410 S Durango Dr Ste 105-110, Las Vegas
Max Pawn Luxury
Max Pawn Luxury
6040 W Sahara Ave, Las VegasStorage

Towne Storage - Buffalo
Towne Storage - Buffalo
7425 S Buffalo Dr, Las Vegas
CubeSmart Self Storage
CubeSmart Self Storage
8265 W Sahara Ave, Las Vegas
Devon Self Storage
Devon Self Storage
3333 Meade Ave, Las Vegas
Towne Storage - Ft. Apache
Towne Storage - Ft. Apache
6630 S Fort Apache Rd, Las Vegas
CubeSmart Self Storage
CubeSmart Self Storage
7650 S Durango Dr, Las Vegas
Green Valley Storage-Blue Diamond
Green Valley Storage-Blue Diamond
8945 Kens Ct, Las Vegas
CubeSmart Self Storage
CubeSmart Self Storage
9325 W Russell Rd, Las Vegas
US Storage Centers
US Storage Centers
233 N Mojave Rd, Las Vegas
CubeSmart Self Storage
CubeSmart Self Storage
3869 Sunset Rd, Las Vegas
CubeSmart Self Storage
CubeSmart Self Storage
1501 N Buffalo Dr, Las Vegas
US Storage Centers
US Storage Centers
3375 Glen Ave, Las Vegas
Fort Apache Self Storage
Fort Apache Self Storage
9345 W Flamingo Rd, Las Vegas
Mini Price Self Storage
Mini Price Self Storage
4675 Boulder Hwy, Las Vegas
US Storage Centers
US Storage Centers
6380 Annie Oakley Dr, Las Vegas
StorQuest Economy Self Storage


















































































